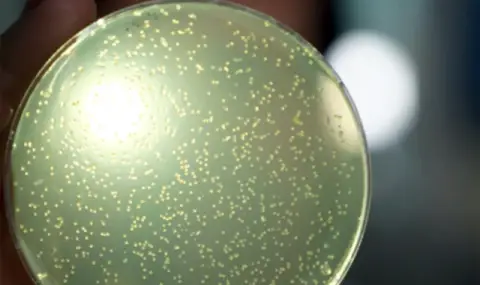
Учени създават изкуствена човешка ДНК от нулата - 1

Британски учени стартираха първия в света проект за създаване на изкуствена човешка ДНК от нулата. В рамките на проекта "Synthetic Human Genome Project" изследователите не просто ще четат ДНК, а ще я сглобяват молекула по молекула, докато създадат пълноценна синтетична хромозома.
Според д-р Джулиан Сейл от Лабораторията по молекулярна биология в Кеймбридж, мащабната работа е насочена към създаване на клетки, устойчиви на заболявания. Тези клетки потенциално биха могли да възстановяват органи като сърцето, черния дроб и цялата имунна система. Важно е да се отбележи, че изследванията ще се провеждат в епруветки и петриеви панички, без опити за създаване на синтетичен живот.
Тази амбициозна инициатива обаче не среща пълна подкрепа в научното общество. Някои учени изразяват опасения, че технологията може да бъде използвана за създаване на биологични оръжия или "подобрени" версии на хора. "Ако някой с подходящото оборудване реши да синтезира каквото и да е, ние няма да можем да го спрем", признава професор Бил Ърншоу от Единбургския университет.

Напиши коментар:
КОМЕНТАРИ КЪМ СТАТИЯТА
1 дарк фючър
Знаете ли, че съвсем наскоро един институт подложи най-известните, към момента изкуствени интелекти на стрест тест и установи, че м/у 80 и 96% от тях, ако бъдат притиснати в ъгъла са склонни да изнудват, рекетират и дори намерят начин да убият човек!?
Накратко събраната и събирана база от лична информация на човеците, се и ще бъде използвана срещу човечеството, ако реши да действа против машините! Звучи ви невероятно, но е факт, а е едва началото!
Филми, като Терминатор, най-вероятно, ще се окажат пророчески!
Коментиран от #5
12:35 08.07.2025
2 молекула по молекула
13:08 08.07.2025
3 дарк фючър
/д-р Чарлз Краутхамер/
14:10 08.07.2025
4 ИзлишенХ
Инак, излишните на пюре и платинен милиард.
20:11 08.07.2025
5 Дааарвин
До коментар #1 от "дарк фючър":
В природата това се нарича естествен подбор. А всяко същество има инстинкт за оцеляване и "притиснато в ъгъла" е готово да направи неща които в обичайната си среда не ги прави.12:43 09.07.2025
6 Селянина с колелото
Коментиран от #7
12:45 09.07.2025
7 Хахахаааа
До коментар #6 от "Селянина с колелото":
Най-вече да бачка 24/7 само заради това ще го направят и щ ебъдем много по-евтини от хуманоидни роботи.09:54 24.10.2025